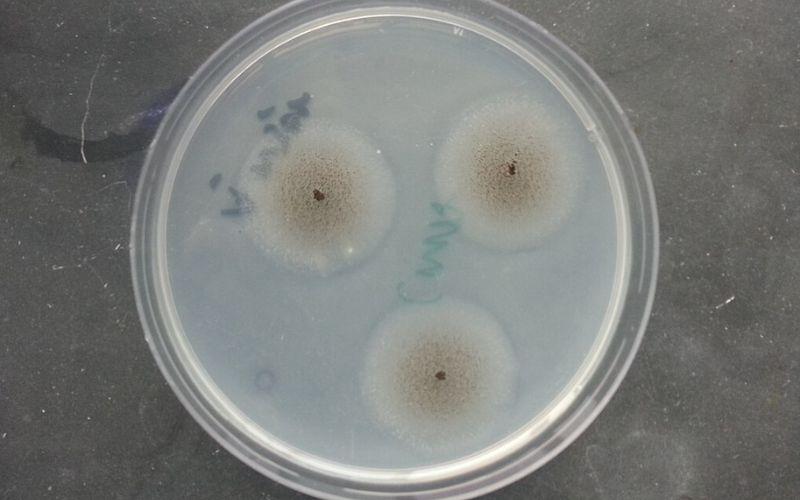
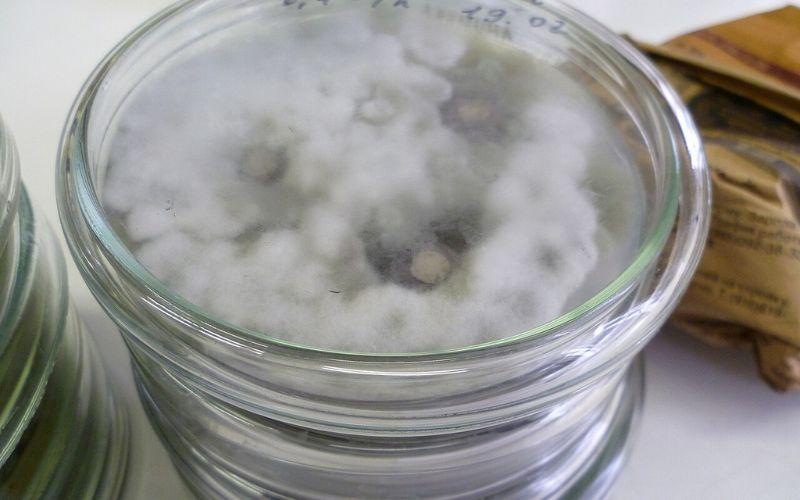

¿Qué son los hongos microscópicos?
Los hongos microscópicos son microorganismos que forman parte del reino Fungi. Pueden ser unicelulares o pluricelulares, como las levaduras y los mohos, respectivamente.
La nutrición de los hongos es heterótrofa, por lo que necesitan alimentarse de sustancias orgánicas elaboradas por otros organismos. Estos hacen digestión externa mediante enzimas que secretan. Después de la digestión, absorben los nutrientes.
Los hongos pueden ser parásitos (se alimentan de su huésped: tiñas, cornezuelo, pie de atleta), saprofitos (se alimentan de materia en descomposición) o simbióticos (algas formando líquenes o raíces de plantas en las microrrizas).
Los hongos son ramificados y generalmente filamentosos. Carecen de clorofila, pero tienen paredes celulares rígidas donde contienen quitina y/o celulosa. En su mayoría son terrestres.
El reino Fungi, o reino de los hongos, cuenta con alrededor de 611.000 especies, número incluso mayor al de las plantas (que cuentan con alrededor de 212.000 especies).
No solo tienen una amplia variedad, tamaños y formas, sino también incontables usos y funciones importantes que regulan el ecosistema, y hasta ciertos procesos del cuerpo humano.
En este caso, se estudiarán diversas especies de hongos que no son tan fáciles de ver a simple vista. Son llamados hongos microscópicos y algunos de ellos tienen papeles muy interesantes y peculiares en algunas condiciones específicas.
Lista de los hongos microscópicos
Candida albicans

Es una levadura saprófita (clasificada como un hongo diploide asexual) que prolifera únicamente dentro del cuerpo humano. Se encuentra generalmente en zonas húmedas del organismo, como la boca, los intestinos delgado y grueso y la vagina.
Usualmente, es mantenido a raya por el sistema inmunológico, y de hecho, cumple una función beneficiosa en el procesamiento de azúcares durante la digestión.
Sin embargo, si por cualquier razón (como defensas bajas o desórdenes alimenticios) el hongo crece excesivamente, puede llegar a generar una enfermedad micótica llamada candidiasis (es muy común que se desarrolle en pacientes con VIH, que ya presentan un daño en su sistema inmunológico).
Esta enfermedad produce distintas afecciones en las zonas donde se aloja, como vaginitis, hongos vaginales e infecciones en la piel, en la cavidad bucal o en el tracto intestinal.
Penicillium chrysogenum

Especie de hongo de la familia Trichocomaceae, más conocida por ser la mejor productora de diversos metabolitos, entre los que se encuentran el antibiótico betalactámico penicilina, descubierto accidentalmente por el científico británico Alexander Fleming en 1928.
Es menester recordar que este medicamento es utilizado para tratar enfermedades que se creían incurables hasta su descubrimiento.
Cryptococcus neoformans

Este hongo puede vivir en plantas y en animales. Es monomórfico, que se transmite por inhalación.
Frecuentemente, se encuentra en el excremento de aves como las palomas. En el ser humano puede provocar la criptococosis pulmonar y neumonía aguda atípica. La principal enfermedad que genera es la meningitis.
Aspergillus
Es filamentoso y se compone de cadenas de células llamadas hifas. Su hábitat natural es el heno y también suele desarrollarse en el suelo, sobre materia en descomposición.
Suele encontrarse con facilidad y su papel es muy importante en la degradación de la materia orgánica. Puede hallarse en hospitales, el suelo, material de construcción, entre otros lugares.
En el ser humano, este hongo suele generar onicomicosis (infección de uñas), otomicosis (infección en el oído), sinusitis alérgica, entre otras enfermedades.
Trichophyton rubrum

Es un hongo dermatofito antropofílico que por lo general causa enfermedades, como el pie de atleta y la tiña. Fue descrito en 1845 por primera vez y su desarrollo puede ser lento o moderadamente rápido.
Rhizopus nigricans

Este es un moho con esporas que se encuentra en el pan. Es del género Rhizopus, al cual pertenecen los hongos esporangios columnares hemiséricos aéreos.
Alternaria alternata
Este hongo en particular se caracteriza por ser patógeno. Puede causar machas en las hojas y enfermedades en diversas especies vegetales, como pudrición y decoloración.
En las personas puede provocar infecciones en el tracto respiratorio superior, además de asma.
Mucor corymbilfer

Esta especie de hongo es saprófita y vive en el suelo. Generalmente, se encuentra en el pan mohoso y las papas en descomposición.
Mucor mucedo

Al igual que la especie anterior, este hongo es saprófito y es común encontrarlo en el suelo. Es el causante de la putrefacción de los alimentos horneados, las frutas y los insectos.
Saccharomyces cerevisiae

Este hongo unicelular es la levadura utilizada en las industrias para fabricar alimentos como el pan, la cerveza y el vino.
Su ciclo de vida se alterna entre la forma haploide y diploide. Su manera de reproducción es asexual.
Schizosaccharomyces pombe

Es una especie de levadura, un hongo unicelular que se usa como organismo modelo de estudio en la biología molecular y biología celular para estudiar el ciclo celular.
También es llamada fission yeast en inglés. Mide de 3 a 4 micrómetros de diámetro y su forma es como la de un bastón. En 1893 fue aislada por primera vez de una cerveza africana. En el idioma swahili, su nombre significa cerveza.
Referencias
- Crowson, R. Classification and Biology. Transaction Publisher.
- Hudson, H. Fungal Biology. CUP Archive.
- Kavanagh, K. Fungi: Biology and Applications. John Wiley & Sons.
- Muntañola, M. Guía de los hongos microscópicos. Omega.
- Prats, G. Microbiología clínica. Ed. Médica Panamericana.